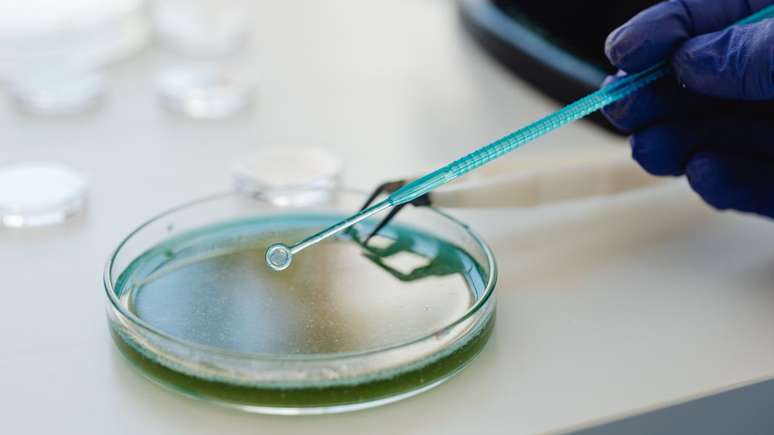
Nem todas as bactérias fazem mal

Você sabia que algumas bactérias são benéficas para o organismo? Entenda
Do intestino humano ao solo fértil, as bactérias são parceiras invisíveis da vida: ajudam na digestão, fortalecem a imunidade, fermentam alimentos e até limpam o planeta
Nem todas as bactérias que estão no nosso organismo são vilãs. Embora muitas vezes sejam lembradas apenas por causarem doenças, há um verdadeiro exército trabalhando a nosso favor - dentro do corpo, na terra, na comida e até no ar que respiramos. Essas bactérias benéficas são essenciais para o equilíbrio da vida e participam de processos vitais como digestão, imunidade, fermentação e regeneração ambiental.
No nosso corpo: guardiãs da saúde intestinal e imunológica
O corpo humano abriga trilhões de microrganismos, e boa parte deles vive no intestino. Lá, eles formam a microbiota intestinal, uma espécie de ecossistema interno que influencia diretamente o sistema imunológico, o metabolismo e até o humor. Conheça algumas espécies:
1. Lactobacillus acidophilus
Presente em iogurtes e suplementos probióticos, ajuda na digestão e na absorção de nutrientes, além de impedir a proliferação de bactérias nocivas. Produz ácido lático, que mantém o pH intestinal equilibrado.
2. Bifidobacterium bifidum e Bifidobacterium longum
São conhecidas por fortalecer o intestino e proteger contra infecções. Essas bactérias ajudam a reduzir inflamações e melhoram a digestão, sendo abundantes no intestino de bebês amamentados.
3. Streptococcus thermophilus
Usada na fermentação de iogurtes e queijos, essa bactéria facilita a digestão da lactose e contribui para uma flora intestinal saudável.
4. Lactobacillus rhamnosus
Além de auxiliar a digestão, é uma das principais aliadas da saúde íntima feminina, prevenindo infecções fúngicas e bacterianas.
5. Propionibacterium freudenreichii
Responsável pelo sabor e pelos característicos "furinhos" do queijo suíço, também participa da produção natural de vitamina B12 no intestino.
6. Saccharomyces boulardii
Usada como probiótico, essa levedura ajuda a tratar diarreias e restaura a flora intestinal após o uso de antibióticos.
Na natureza: o papel essencial das bactérias no meio ambiente
Essas pequenas formas de vida também sustentam o equilíbrio do planeta. Elas participam da decomposição de matéria orgânica, da fertilização do solo e até da purificação de ambientes contaminados.
1. Rhizobium e Azospirillum brasilense
Essas bactérias vivem em simbiose com as raízes de plantas leguminosas, como feijão e ervilha, ajudando na fixação do nitrogênio, nutriente essencial para o crescimento vegetal.
2. Nitrosomonas
Transforma amônia em nitritos, etapa fundamental no ciclo do nitrogênio que mantém o solo fértil.
3. Pseudomonas putida
É uma aliada contra a poluição: tem capacidade de degradar pesticidas e metais pesados, sendo estudada como ferramenta na limpeza de solos e águas contaminadas.
4. Deinococcus radiodurans
Considerada uma das bactérias mais resistentes do mundo, sobrevive a níveis extremos de radiação e calor. Por isso, está sendo estudada para limpar resíduos radioativos e até proteger astronautas no espaço.
5. Bacillus thuringiensis
Usada na agricultura orgânica, atua como pesticida natural, protegendo as plantações sem prejudicar o meio ambiente.
6. Azospirillum e Bacillus subtilis
Melhoram a saúde do solo e são empregadas em biofertilizantes, reduzindo a dependência de produtos químicos.
Nos alimentos: as responsáveis pelo sabor e pela vitalidade
As bactérias também têm papel importante na cozinha. Elas fermentam, curam e transformam alimentos, tornando-os mais nutritivos e fáceis de digerir.
1. Lactococcus lactis e Streptomyces
Essenciais na fabricação de queijos e produtos fermentados, também têm aplicações na medicina e na biotecnologia.
2. Acetobacter
É o microrganismo por trás do vinagre e da kombucha, convertendo o álcool em ácido acético e conferindo o sabor característico às bebidas fermentadas.
3. Saccharomyces cerevisiae
Usada na panificação e na produção de cerveja, essa levedura é uma das mais estudadas pela ciência - e até já ajudou na criação de medicamentos e biocombustíveis.
Pequenas, mas indispensáveis
As bactérias são, em essência, o alicerce invisível da vida. Dentro e fora do corpo, elas sustentam ecossistemas inteiros, promovem saúde, reciclam nutrientes e equilibram o planeta. Cuidar do próprio organismo, com alimentação equilibrada e rica em alimentos probióticos, é também uma forma de respeitar esse universo microscópico que trabalha, silenciosamente, por todos nós.

-ubp6nxp2wqqs.jpg)










Comentários
As opiniões expressas nos comentários são de responsabilidade exclusiva de seus autores e não representam a opinião do Terra.